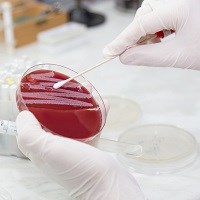
Antibiotic resistance is now “common” in urinary tract infections

National Institute for Health and Clinical Excellence (NICE)
|
|
Antibiotic resistance is now “common” in urinary tract infections
The number of urinary tract infections (UTIs) caused by drug resistant bacteria is increasing, new data shows.
The 'English Surveillance Programme for Antimicrobial Utilisation and Resistance’ (ESPAUR) report says more than one million UTI samples were analysed in NHS laboratories across England last year (2016), and that resistance was a “common” observation.
One in three (34%) of the samples analysed were found to be resistant to an antibiotic called trimethoprim, compared to 29.1% in 2015.
Trimethoprim was once the first choice treatment for UTIs before Public Health England (PHE) recommended switching to a different antibiotic called nitrofurantoin. Only 3% of the UTI samples showed resistance to nitrofurantoin, the report says.
Inappropriate use of antibiotics, such as taking them for viral conditions like flu, or for mild infections that may clear-up without treatment is known to fuel resistance.
NICE recently updated its guidance for managing UTIs in children. New recommendations focus on using urine dipstick tests to identify whether antibiotic treatment is needed.
Professor Gillian Leng, deputy chief executive at NICE said: “Antibiotic resistance is one of the greatest dangers to our health, which is why we must all work together to fight it.
“Making sure that we use these medicines properly, only when they are really needed, is vital. And our guidance is here to help healthcare professionals navigate these sometimes difficult decisions.”
This year saw the launch of NICE’s ‘Management of Common Infections’ (MoCI) guidelines. The suite of new guidance seeks to provide evidence-based advice on how common infections can be managed, with the purpose of tackling antibiotic resistance. UTIs are one of the common infections the NICE MoCI committee will be looking into.
“I hope this new advice from NICE will help to support better ways of using our current antibiotics as well as protecting new antimicrobials for future generations” Professor Leng added.
Original article link: https://www.nice.org.uk/news/article/antibiotic-resistance-is-now-common-in-urinary-tract-infections


